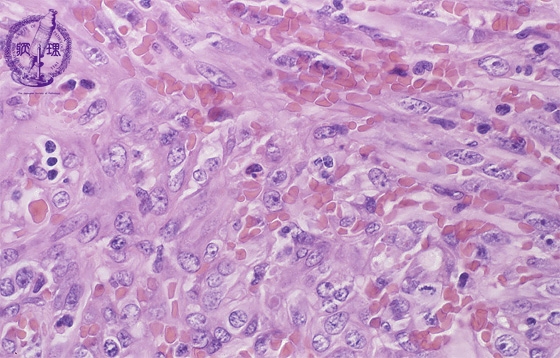
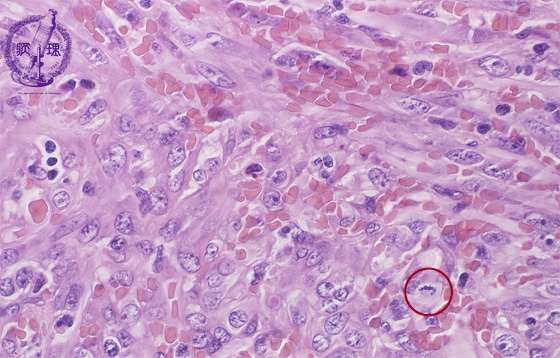

- 18.Soft tissue
- (9)Kaposi sarcoma
Microscopic findings (H.E. high power view): Spindle tumor cells detected in irregular vascular channels surrounded by swollen atypical endothelial cells, like angiosarcoma. Mitotic figures (circle) are frequently detected.
Click the image to see the enlarged image.